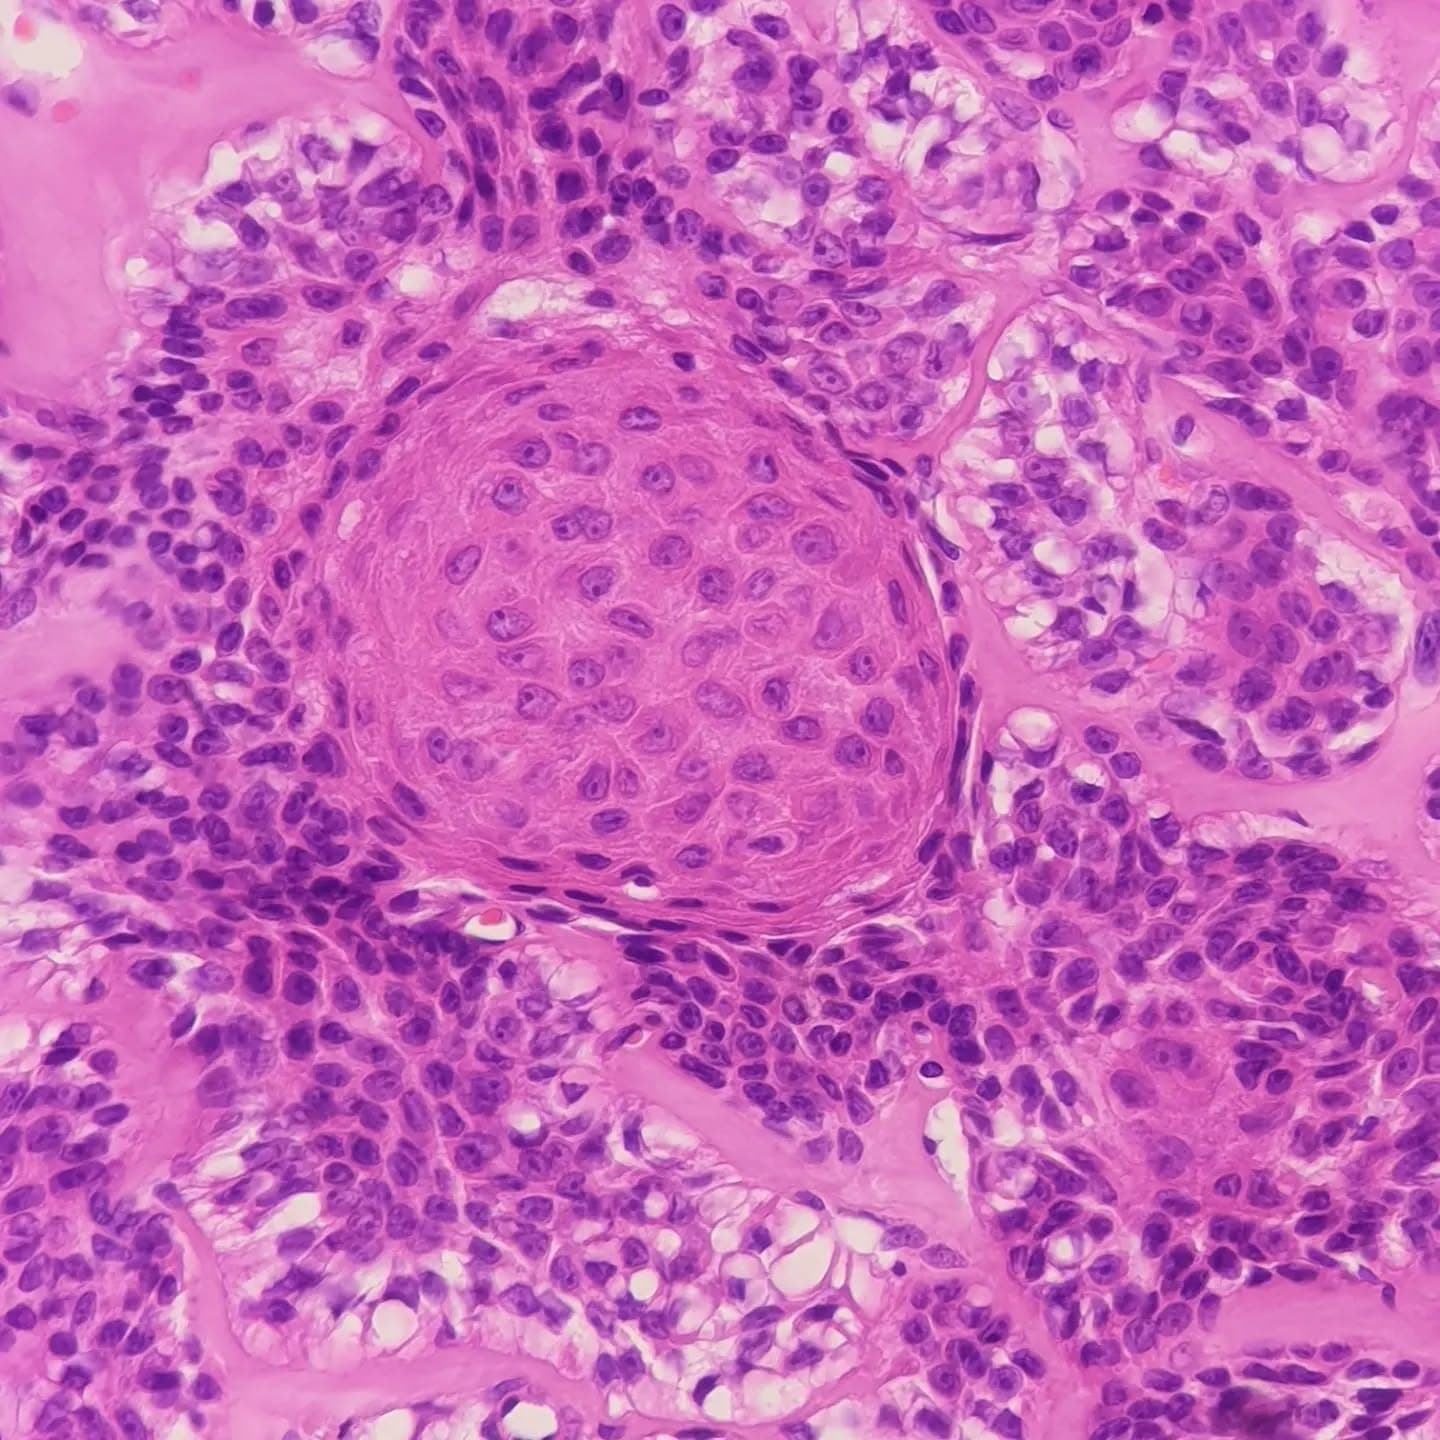
A 46 y/o woman with a sole lesion.
A well-defined mass with epithelial lobules composed of two cell populations (slide 1, 2, 6, 7):
1. Polygonal cells with eosinophilic cytoplasm, arranged in whorls (slide 8),
2. Cells with clear cytoplasm and a small dark eccentric nuclei (slide 4).
Few duct-like structures were seen (slide 5). Some cystic areas were also found (slide 9).
Squamous differentiation and keratin pearls (slide 2, 3), as well as sebaceous differentiation (slide 10) were identified.
The lesion has it all for the diagnosis of HIDRADENOMA!

Back to Posts
June 28, 2023
Photo 1 of 10
professionaly/owoman
Caption: A 46 y/o woman with a sole lesion. A well-defined mass with epithelial lobules composed of two cell populations (slide 1, 2, 6, 7): 1. Polygonal cells with eosinophilic cytoplasm, arranged in whorls (slide 8), 2. Cells with clear cytoplasm and a small dark eccentric nuclei (slide 4). Few duct-like structures were seen (slide 5). Some cystic areas were also found (slide 9). Squamous differentiation and keratin pearls (slide 2, 3), as well as sebaceous differentiation (slide 10) were identified. The lesion has it all for the diagnosis of HIDRADENOMA!